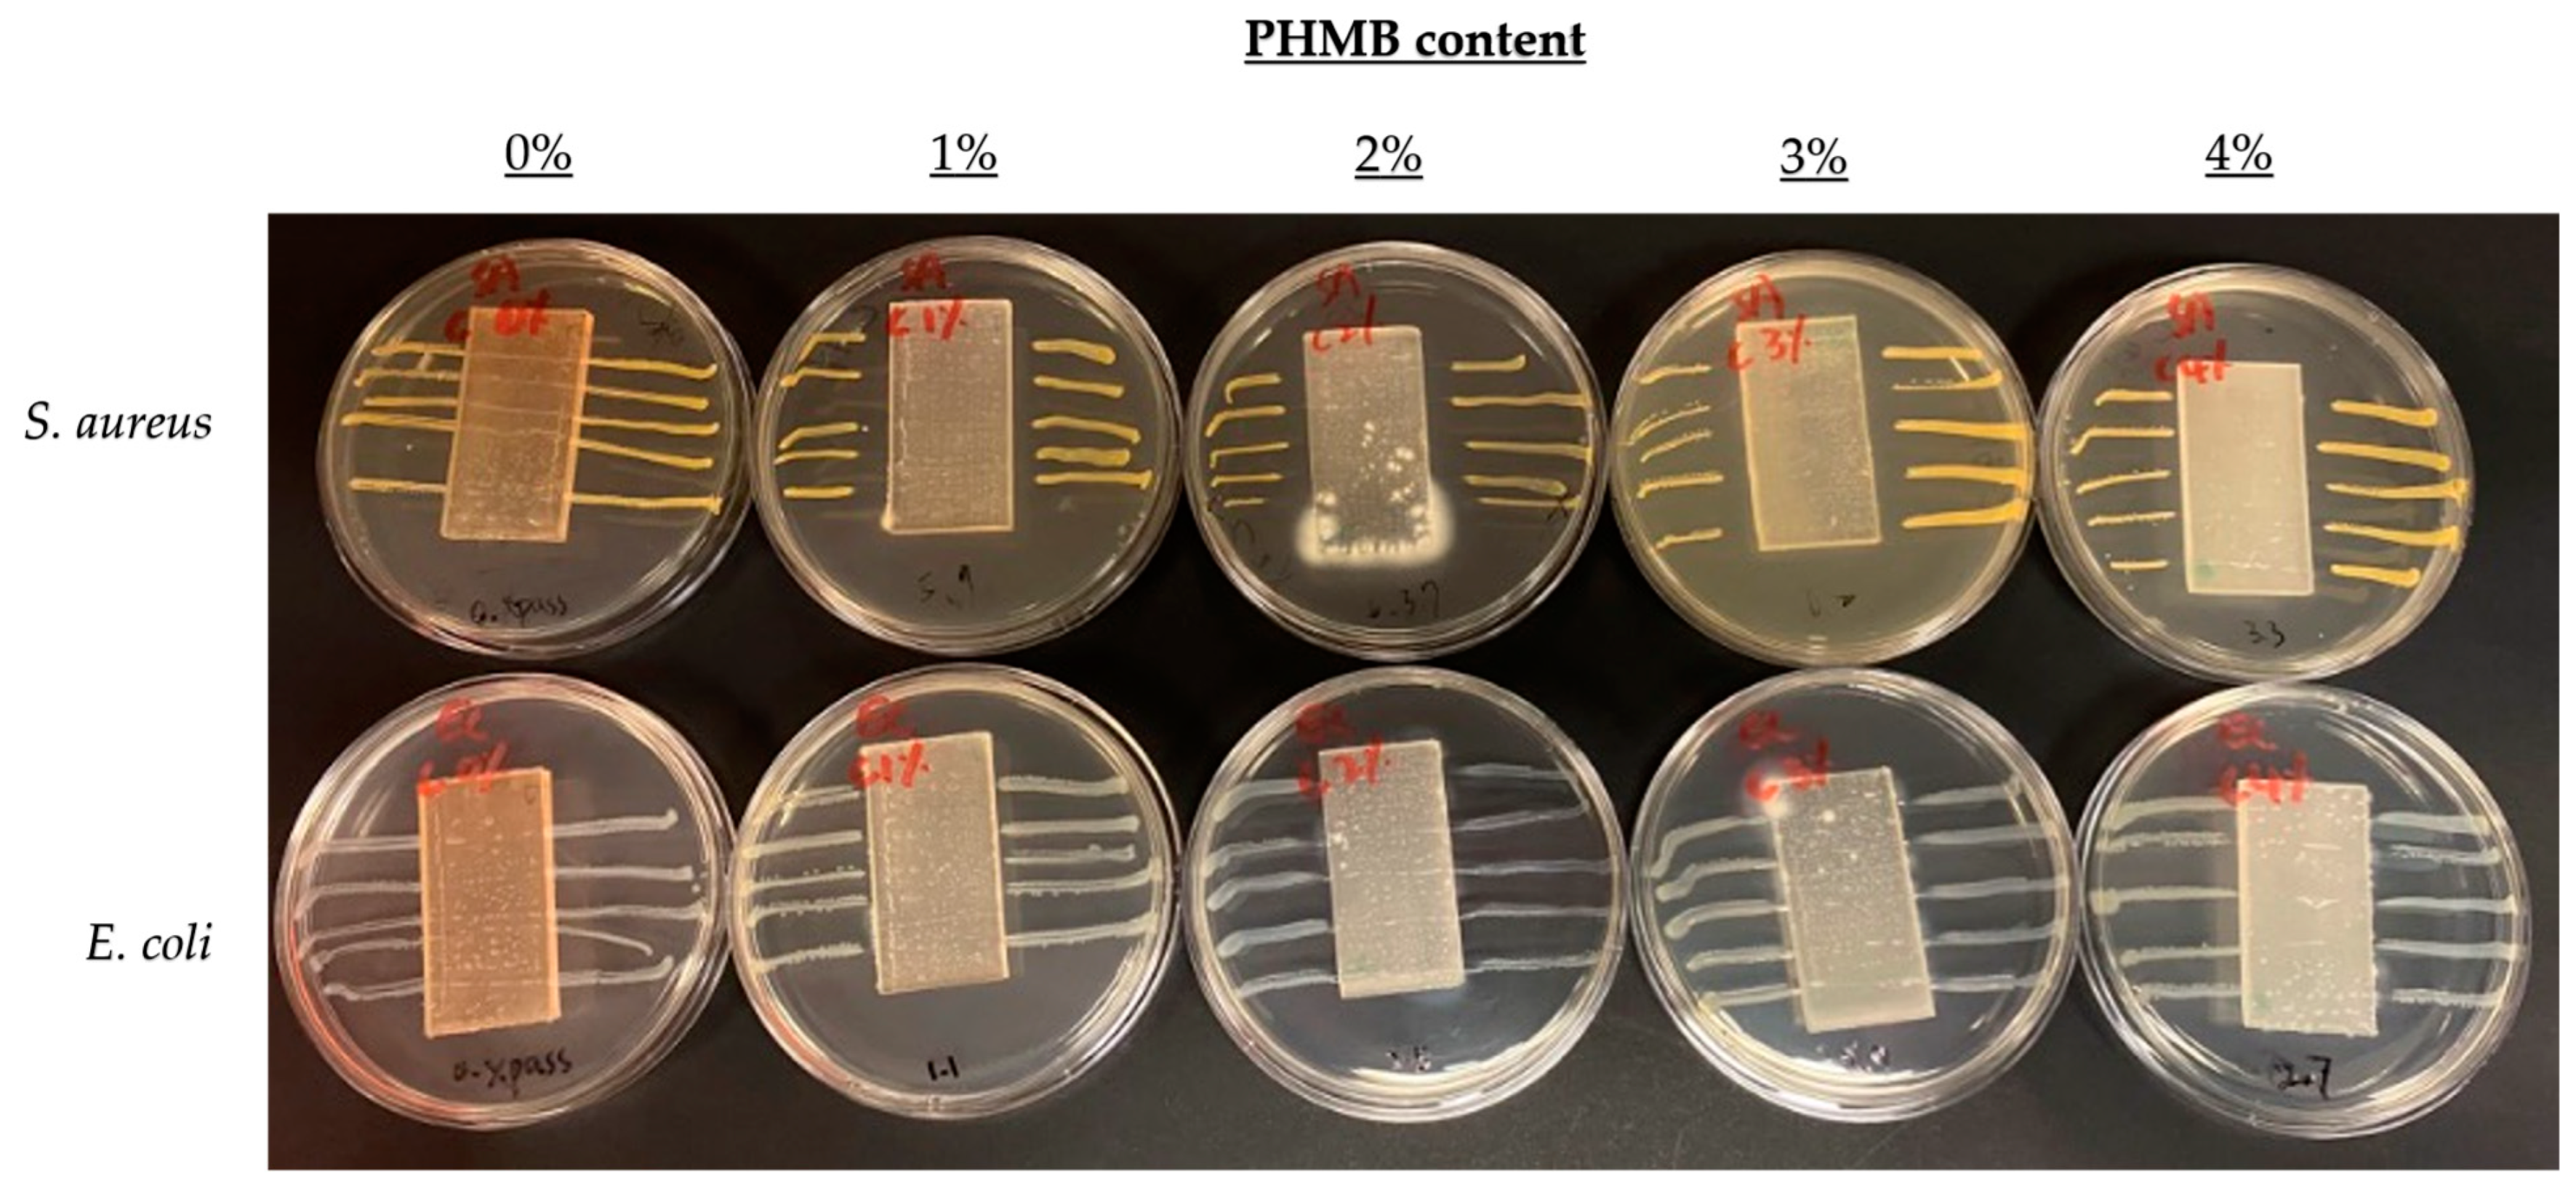
Polymers 16 00312 g005
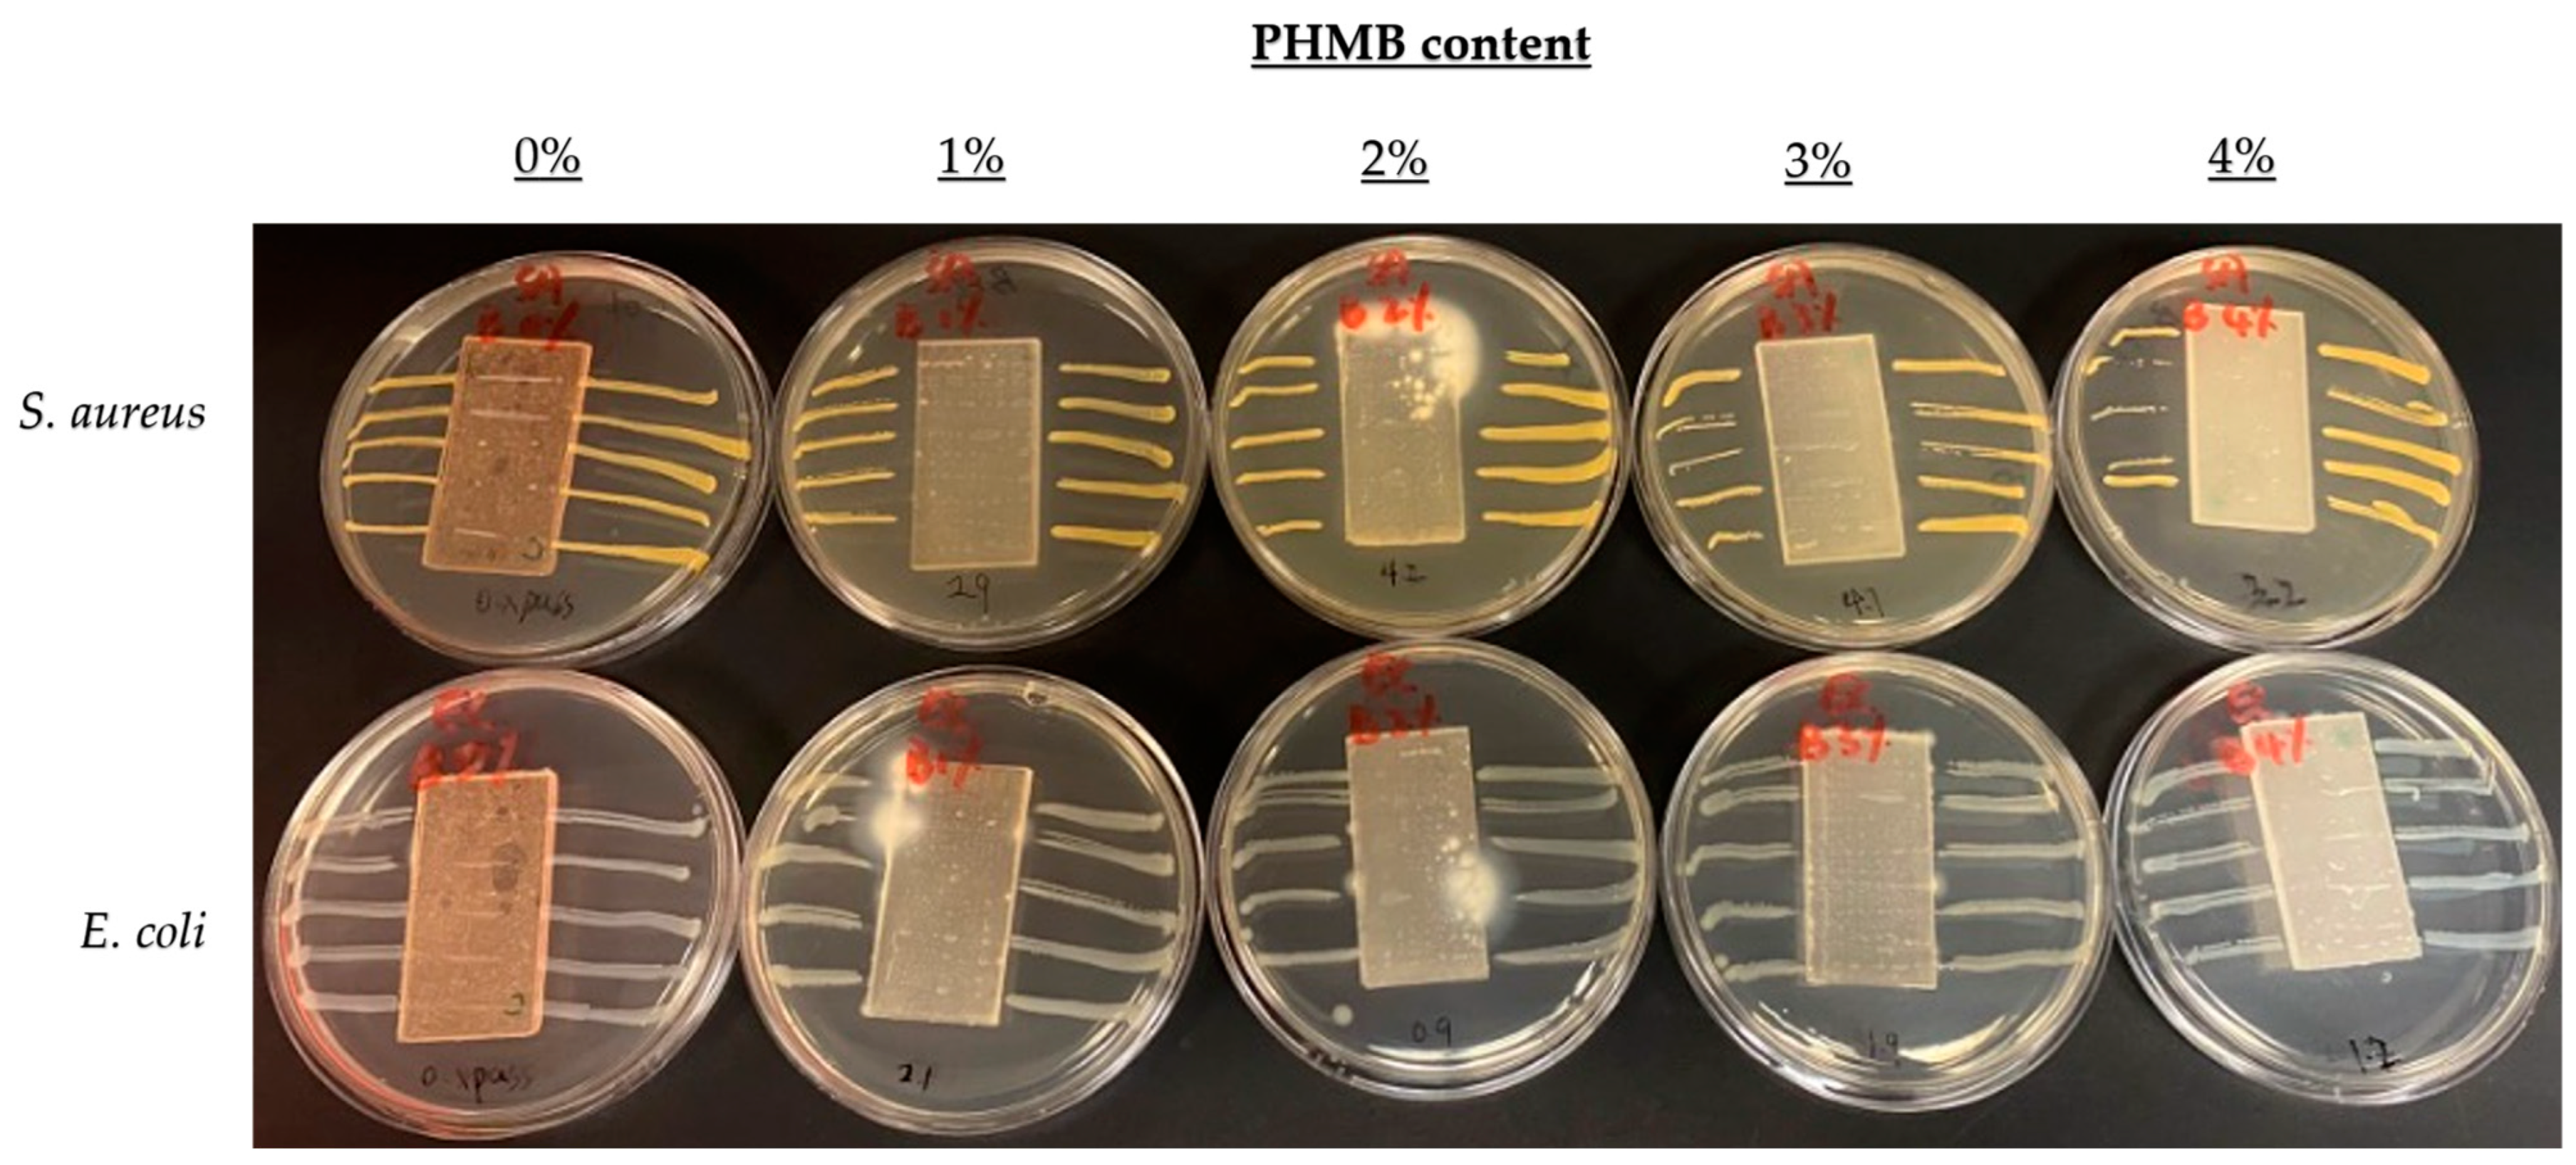
Polymers 16 00312 g007
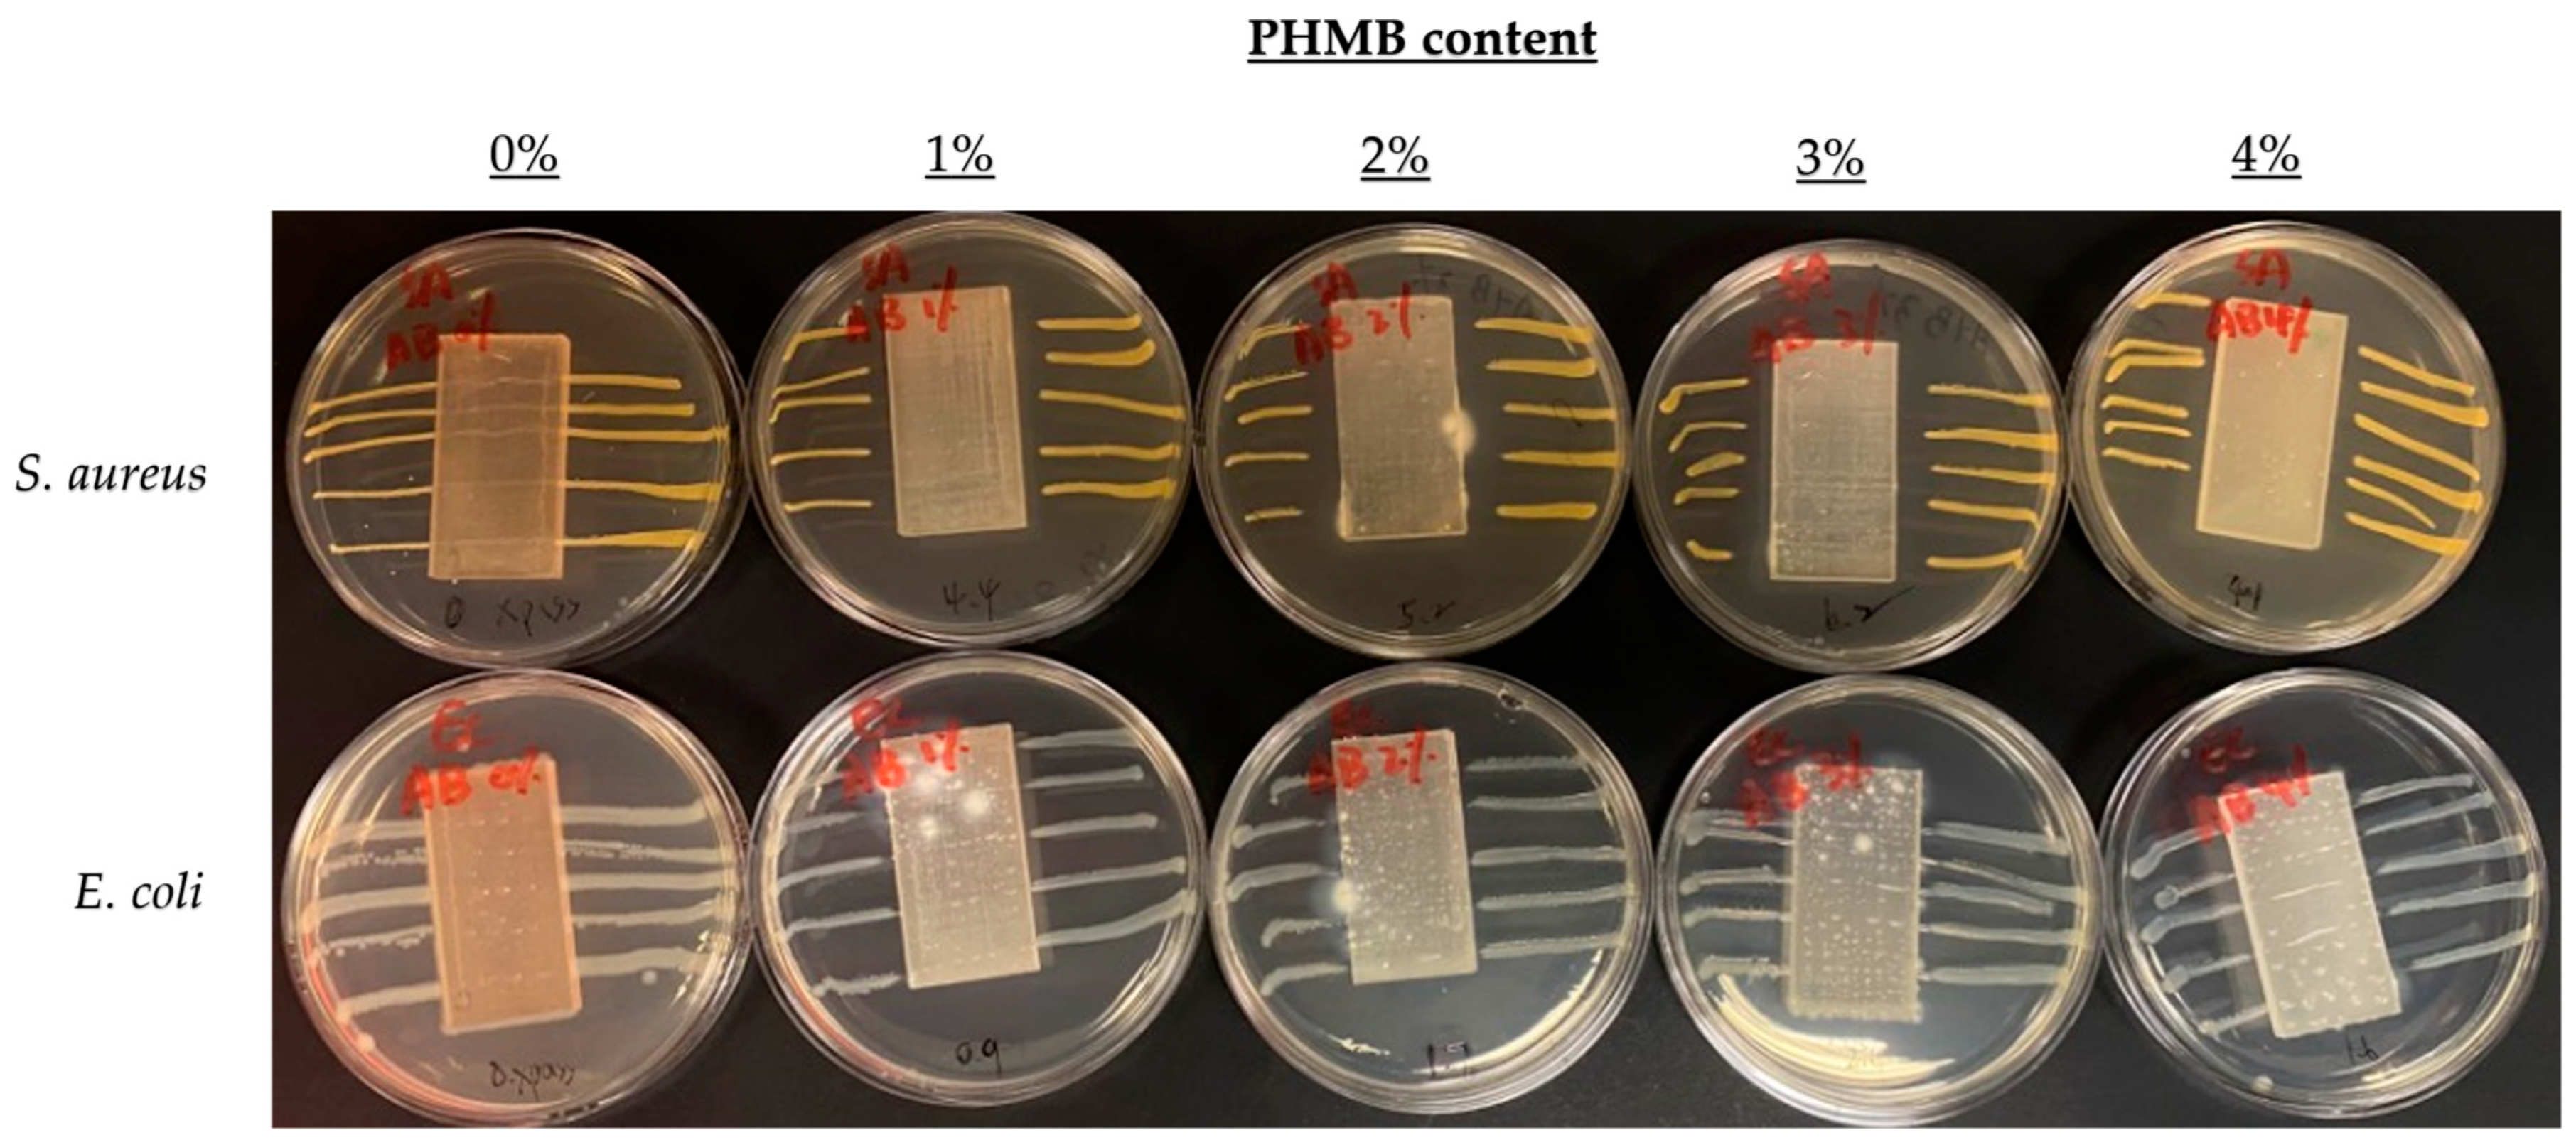
Polymers 16 00312 g008

Antiviral and Antibacterial 3D-Printed Products Functionalised with Poly(hexamethylene biguanide)
Abstract
1. Introduction
2. Materials and Methods
2.1. Materials
2.2. Fabrications of Antimicrobial Samples and Covers
2.2.1. Preparation of PHMB Solution
2.2.2. Preparation of Antimicrobial Printing Resin
2.2.3. Three-Dimensional Printing and Post-Treatments of Antimicrobial Materials
2.2.4. Preparation of Abraded and/or Bleach-Rubbed Samples
2.3. Characterisation of 3D-Printed Samples Doped with PHMB by Decolourisation of BPB Solution
2.4. Quantitative Assessments of Antimicrobial Efficacies of 3D-Printed Samples in Lab Tests
2.4.1. Antibacterial Activities by ISO 22196:2011
2.4.2. Inhibition Zone Determination by AATCC TM 147:2011
2.4.3. Antiviral Performances by ISO 21702:2019
2.5. Biological Reactivity Test, In Vivo, by USP General Chapter <88>
2.6. Quantitative Examination of Antibacterial Effectiveness of 3D-Printed Covers by Field Test
3. Results and Discussion
3.1. Characterisation of Antimicrobial 3D-Printed Samples by Decolourisation of BPB Solution
3.2. Antibacterial Performances against E. coli and S. aureus by ISO 22196
3.3. Comparison of Inhibition Zones Formed against E. coli and S. aureus by AATCC 147
3.4. Inhibition Zones Formed against K. pneumoniae and S. aureus by AATCC 147
3.5. Antiviral Activity of 3D-Printed Samples by ISO 21702
3.6. Biological Reactivity Test, In Vivo, by USP General Chapter <88>
3.7. Antibacterial Activities of 3D-Printed Covers in Hong Kong Wetland Park
4. Conclusions
Author Contributions
Funding
Institutional Review Board Statement
Data Availability Statement
Acknowledgments
Conflicts of Interest
References
- Otter, J.A.; Yezli, S.; Salkeld, J.A.; French, G.L. Evidence that contaminated surfaces contribute to the transmission of hospital pathogens and an overview of strategies to address contaminated surfaces in hospital settings. Am. J. Infect. Control 2013, 41, S6–S11. [Google Scholar] [CrossRef] [PubMed]
- Weber, D.J.; Rutala, W.A.; Anderson, D.J.; Chen, L.F.; Sickbert-Bennett, E.E.; Boyce, J.M. Effectiveness of ultraviolet devices and hydrogen peroxide systems for terminal room decontamination: Focus on clinical trials. Am. J. Infect. Control 2016, 44, e77–e84. [Google Scholar] [CrossRef] [PubMed]
- Van Doremalen, N.; Bushmaker, T.; Morris, D.H.; Holbrook, M.G.; Gamble, A.; Williamson, B.N.; Tamin, A.; Harcourt, J.L.; Thornburg, N.J.; Gerber, S.I.; et al. Aerosol and Surface Stability of SARS-CoV-2 as Compared with SARS-CoV-1. N. Engl. J. Med. 2020, 382, 1564–1567. [Google Scholar] [CrossRef]
- Blanco, N.; Eisenberg, M.C.; Stillwell, T.; Foxman, B. What transmission precautions best control influenza spread in a hospital? Am. J. Epidemiol. 2016, 183, 1045–1054. [Google Scholar] [CrossRef] [PubMed]
- Boyce, J.M. Modern technologies for improving cleaning and disinfection of environmental surfaces in hospitals. Antimicrob. Resist. Infect. Control 2016, 5, 10. [Google Scholar] [CrossRef]
- Widsten, P.; Salo, S.; Hakkarainen, T.; Nguyen, T.L.; Borrega, M.; Fearon, O. Antimicrobial and flame-retardant coatings prepared from nano- and microparticles of unmodified and nitrogen-modified polyphenols. Polymers 2023, 15, 992. [Google Scholar] [CrossRef]
- Babutan, I.; Lucaci, A.-D.; Botiz, I. Antimicrobial polymeric structures assembled on surfaces. Polymers 2021, 13, 1552. [Google Scholar] [CrossRef]
- Sousa, B.C.; Cote, D.L. Antimicrobial copper cold spray coatings and SARS-CoV-2 surface inactivation. MRS Adv. 2020, 5, 2873–2880. [Google Scholar] [CrossRef]
- Lucas, M.; Botef, I.; Reid, R.G.; van Vuuren, S.F. Laboratory-based study of novel antimicrobial cold spray coatings to combat surface microbial contamination. Infect. Control. Hosp. Epidemiol. 2020, 41, 1378–1383. [Google Scholar] [CrossRef]
- Denis-Rohr, A.; Bastarrachea, L.J.; Goddard, J.M. Antimicrobial efficacy of N-halamine coatings prepared via dip and spray layer-by-layer deposition. Food Bioprod. Process. 2015, 96, 12–19. [Google Scholar] [CrossRef]
- Ferreira, T.P.; Nepomuceno, N.C.; Medeiros, E.L.; Medeiros, E.S.; Sampaio, F.C.; Oliveira, J.E.; Oliveira, M.P.; Galvão, L.S.; Bulhões, E.O.; Santos, A.S. Antimicrobial coatings based on poly(dimethyl siloxane) and silver nanoparticles by solution blow spraying. Prog. Org. Coat. 2019, 133, 19–26. [Google Scholar] [CrossRef]
- El-Sayed, M.; Al-Mofty, S.E.-D.; Mahdy, N.K.; Sarhan, W.A.; Azzazy, H.M.E.-S. A novel long-acting antimicrobial nanomicelle spray. Nanoscale Adv. 2023, 5, 2517–2529. [Google Scholar] [CrossRef]
- Buhl, S.; Peter, J.; Stich, A.; Brückner, R.; Bulitta, C. Durability and stability of antimicrobial coated surfaces. Curr. Dir. Biomed. Eng. 2020, 6, 298–300. [Google Scholar] [CrossRef]
- Nguyen, T.V.; Nguyen, T.A.; Dao, P.H.; Mac, V.P.; Nguyen, A.H.; Do, M.T.; Nguyen, T.H. Effect of rutile titania dioxide nanoparticles on the mechanical property, thermal stability, weathering resistance and antibacterial property of styrene acrylic polyurethane coating. Adv. Nat. Sci. Nanosci. Nanotechnol. 2016, 7, 45015. [Google Scholar] [CrossRef]
- Yemmireddy, V.K.; Hung, Y. Using photocatalyst metal oxides as antimicrobial surface coatings to ensure food safety—opportunities and challenges. Compr. Rev. Food Sci. Food Saf. 2017, 16, 617–631. [Google Scholar] [CrossRef]
- Villanueva, M.E.; Ghibaudo, M.F.; Tovar, G.I.; Copello, G.J.; Orto, V.C.D. Oligomer-stabilized silver nanoparticles for antimicrobial coatings for plastics. Nano-Struct. Nano-Objects 2020, 24, 100610. [Google Scholar] [CrossRef]
- Siddiqi, K.S.; Husen, A. Current status of plant metabolite-based fabrication of copper/copper oxide nanoparticles and their applications: A review. Biomater. Res. 2020, 24, 11. [Google Scholar] [CrossRef]
- Liu, W.; Wang, T.; Tao, Y.; Ling, Z.; Huang, C.; Lai, C.; Yong, Q. Fabrication of anti-bacterial, hydrophobic and UV resistant galactomannan-zinc oxide nanocomposite films. Polymer 2021, 215, 123412. [Google Scholar] [CrossRef]
- Liao, C.; Li, Y.; Tjong, S.C. Visible-light active titanium dioxide nanomaterials with bactericidal properties. Nanomaterials 2020, 10, 124. [Google Scholar] [CrossRef]
- Rocca, D.M.; Aiassa, V.; Zoppi, A.; Compagnucci, J.S.; Becerra, M.C. Nanostructured gold coating for prevention of biofilm development in medical devices. J. Endourol. 2020, 34, 345–351. [Google Scholar] [CrossRef]
- Erkoc, P.; Ulucan-Karnak, F. Nanotechnology-based antimicrobial and antiviral surface coating strategies. Prosthesis 2021, 3, 25–52. [Google Scholar] [CrossRef]
- Makvandi, P.; Wang, C.Y.; Zare, E.N.; Borzacchiello, A.; Niu, L.N.; Tay, F.R. Metal-based nanomaterials in biomedical applications: Antimicrobial activity and cytotoxicity aspects. Adv. Funct. Mater. 2020, 30, 1910021. [Google Scholar] [CrossRef]
- WOW! Webmagazine. Antibacterial Coatings with Silver Ions to Reduce the Viral Load of Objects. 2020. Available online: https://wow-webmagazine.com/antibacterial-coatings-with-silver-ions-to-reduce-the-viral-load-of-objects (accessed on 8 July 2023).
- Sim, W.; Barnard, R.T.; Blaskovich, M.A.T.; Ziora, Z.M. Antimicrobial silver in medicinal and consumer applications: A patent review of the past decade (2007–2017). Antibiotics 2018, 7, 93. [Google Scholar] [CrossRef]
- Greulich, C.; Braun, D.; Peetsch, A.; Diendorf, J.; Siebers, B.; Epple, M.; Köller, M. The toxic effect of silver ions and silver nanoparticles towards bacteria and human cells occurs in the same concentration range. RSC Adv. 2012, 2, 6981–6987. [Google Scholar] [CrossRef]
- Mijnendonckx, K.; Leys, N.; Mahillon, J.; Silver, S.; Van Houdt, R. Antimicrobial silver: Uses, toxicity and potential for resistance. BioMetals 2013, 26, 609–621. [Google Scholar] [CrossRef]
- Wilkinson, L.J.; White, R.J.; Chipman, J.K. Silver and nanoparticles of silver in wound dressings: A review of efficacy and safety. J. Wound Care 2011, 20, 543–549. [Google Scholar] [CrossRef]
- Lansdown, A.B.G. Silver in health care: Antimicrobial effects and safety in use. In Biofunctional Textiles and the Skin; Hipler, U.C., Elsner, P., Eds.; S. Karger AG: Basel, Switzerland, 2006; pp. 17–34. [Google Scholar]
- Dos Santos, C.A.; Seckler, M.M.; Ingle, A.P.; Gupta, I.; Galdiero, S.; Galdiero, M.; Gade, A.; Rai, M. Silver nanoparticles: Therapeutical uses, toxicity, and safety issues. J. Pharm. Sci. 2014, 103, 1931–1944. [Google Scholar] [CrossRef]
- Butcher, M. PHMB: An effective antimicrobial in wound bioburden management. Br. J. Nurs. 2012, 21, S16–S21. [Google Scholar] [CrossRef]
- Lucas, A.D.; Gordon, E.A.; Stratmeyer, M.E. Analysis of polyhexamethylene biguanide in multipurpose contact lens solutions. Talanta 2009, 80, 1016–1019. [Google Scholar] [CrossRef]
- Romanowski, E.G.; Yates, K.A.; O’connor, K.E.; Mah, F.S.; Shanks, R.M.Q.; Kowalski, R.P. Evaluation of polyhexamethylene biguanide (PHMB) as a disinfectant for adenovirus. JAMA Ophthalmol. 2013, 131, 495–498. [Google Scholar] [CrossRef][Green Version]
- Wang, W.-Y.; Chiou, J.-C.; Chen, W.-X.; Yu, J.-L.; Kan, C.-W. Biosafety evaluation and quantitative determination of poly(hexamethylene biguanide) (PHMB) coated on cellulosic fabrics by Kubelka–Munk equation. Cellulose 2021, 28, 6651–6661. [Google Scholar] [CrossRef]
- Kramer, A.; Eberlein, T.; Müller, G.; Dissemond, J.; Assadian, O. Re-evaluation of polihexanide use in wound antisepsis in order to clarify ambiguities of two animal studies. J. Wound Care 2019, 28, 246–255. [Google Scholar] [CrossRef]
- Eberlein, T.; Haemmerle, G.; Signer, M.; Gruber-Moesenbacher, U.; Traber, J.; Mittlboeck, M.; Abel, M.; Strohal, R. Comparison of PHMB-containing dressing and silver dressings in patients with critically colonised or locally infected wounds. J. Wound Care 2012, 21, 12–20. [Google Scholar] [CrossRef]
- Murata, H.; Koepsel, R.R.; Matyjaszewski, K.; Russell, A.J. Permanent, non-leaching antibacterial surfaces—2: How high density cationic surfaces kill bacterial cells. Biomaterials 2007, 28, 4870–4879. [Google Scholar] [CrossRef]
- Ferreira, L.; Zumbuehl, A. Non-leaching surfaces capable of killing microorganisms on contact. J. Mater. Chem. 2009, 19, 7796–7806. [Google Scholar] [CrossRef]
- Wang, W.-Y.; Yim, S.-L.; Wong, C.-H.; Kan, C.-W. Study on the development of antiviral spandex fabric coated with poly(hexamethylene biguanide) hydrochloride (PHMB). Polymers 2021, 13, 2122. [Google Scholar] [CrossRef]
- Quan, H.; Zhang, T.; Xu, H.; Luo, S.; Nie, J.; Zhu, X. Photo-curing 3D printing technique and its challenges. Bioact. Mater. 2020, 5, 110–115, Erratum in Bioact. Mater. 2021, 6, 1789–1790. [Google Scholar] [CrossRef]
- Kubiak, B.; Piszczek, P.; Radtke, A.; Muzioł, T.; Wrzeszcz, G.; Golińska, P. Photocatalytic and antimicrobial activity of titanium(IV)-oxo clusters of different core structure. Crystals 2023, 13, 998. [Google Scholar] [CrossRef]
- Śmigiel, J.; Piszczek, P.; Wrzeszcz, G.; Jędrzejewski, T.; Golińska, P.; Radtke, A. The composites of PCL and tetranuclear titanium(IV)–oxo complex with acetylsalicylate ligands—Assessment of their biocompatibility and antimicrobial activity with the correlation to EPR spectroscopy. Materials 2023, 16, 297. [Google Scholar] [CrossRef]
- Kubiak, B.; Radtke, A.; Topolski, A.; Wrzeszcz, G.; Golińska, P.; Kaszkowiak, E.; Sobota, M.; Włodarczyk, J.; Stojko, M.; Piszczek, P. The composites of PCL and tetranuclear titanium(IV)-oxo complexes as materials exhibiting the photocatalytic and the antimicrobial activity. Int. J. Mol. Sci. 2021, 22, 7021. [Google Scholar] [CrossRef]
- ISO 22196:2011(en); Plastics—Measurement of Antibacterial Activity on Plastics and Other Non-Porous Surfaces. ISO: Geneva, Switzerland, 2011.
- AATCC TM147-2011(2016)e; Antibacterial Activity of Textile Materials: Parallel Streak. American Association of Textile Chemists and Colorists: Triangle Park, NC, USA, 2011.
- ISO 21702:2019(en); Plastics—Measurement of Antiviral Activity on Plastics and Other Non-Porous Surfaces. ISO: Geneva, Switzerland, 2019.
- Cheung, E.; Magramo, K.; Cheng, L. Coronavirus: Hong Kong’s fourth wave of COVID-19 Cases Has Ended but Don’t Ease Rules Yet, Government Pandemic Adviser Says. South China Morning Post. 29 May 2021. Available online: https://www.scmp.com/news/hong-kong/health-environment/article/3135325/coronavirus-hong-kongs-fourth-wave-covid-19-cases (accessed on 23 July 2023).
- Wang, W.-Y.; Kan, C.-W. An eco-friendly dyeing method: Bromophenol blue (BPB) applied for dyeing cotton fabrics coated with cationic finishing agents. Cellulose 2020, 27, 9045–9059. [Google Scholar] [CrossRef]
- Liu, D.X.; Liang, J.Q.; Fung, T.S. Human Coronavirus-229E, -OC43, -NL63, and -HKU1 (Coronaviridae). Encycl. Virol. 2021, 2, 428–440. [Google Scholar] [CrossRef]
- Therapeutic Goods Administration, Department of Health and Aged Care. Surrogate Viruses for Use in Disinfectant Efficacy Tests to Justify Claims against COVID-19. 2022. Available online: https://www.tga.gov.au/resources/resource/guidance/surrogate-viruses-use-disinfectant-efficacy-tests-justify-claims-against-covid-19 (accessed on 8 July 2023).

| Bacteria Contact Hour | |||||
|---|---|---|---|---|---|
| Post-Treatment | S. aureus (CFU/mL) | E. coli (CFU/mL) | |||
| PHMB % w/w | 0 | 24 | 0 | 24 | |
| No treatment | 0 | 1.72 × 106 | 2.21 × 109 | 4.10 × 105 | 2.59 × 1010 |
| 2 | 0 | 0 | 0 | 0 | |
| 3 | 0 | 0 | 0 | 0 | |
| Abraded with sandpaper | 0 | 1.94 × 106 | 1.85 × 109 | 6.80 × 106 | 8.82 × 1010 |
| 2 | 1.13 × 106 | 0 | 0 | 0 | |
| 3 | 2.05 × 106 | 0 | 0 | 0 | |
| Cleaned with 1:49 household bleach solution | 0 | 1.96 × 106 | 2.17 × 108 | 1.23 × 106 | 9.18 × 109 |
| 2 | 1.40 × 106 | 0 | 0 | 0 | |
| 3 | 0 | 0 | 0 | 0 | |
| Cleaned with 1:49 household bleach solution and then abraded with sandpaper | 0 | 1.66 × 106 | 2.69 × 108 | 1.05 × 109 | 1.34 × 1012 |
| 2 | 0 | 0 | 0 | 0 | |
| 3 | 0 | 0 | 6.80 × 105 | 0 | |
| K. pneumoniae | S. aureus | |||||
|---|---|---|---|---|---|---|
| PHMB Content (% w/w) | Without Post-Treatment | Abraded with Sandpaper | Cleaned with 1:49 Bleach Solution | Without Post-Treatment | Abraded with Sandpaper | Cleaned with 1:49 Bleach Solution |
| 0 | 0 | 0 | 0 | 0 | 0 | 0 |
| 3 | 3.0 | 1.1 | 1.2 | 3.6 | 3.3 | 3.3 |
| Infectivity Titre Value Immediate after Inoculation of the Reference Specimen | Infectivity Titre Value after 2 h Contacting with the Reference Specimen | Infectivity Titre Value after 2 h Contacting with the ERF-A Sample with 0% PHMB | Infectivity Titre Value after 2 h Contacting with the ERF-A Sample with 3% PHMB | |
|---|---|---|---|---|
| Average logarithm of infectivity titre value (lgTCID50/mL) | 5.81 | 5.17 | 4.12 | 2.17 |
| Average logarithm of infectivity titre value (lgTCID50/cm2) | 5.61 | 4.97 | 3.92 | 1.97 |
| Average infectivity titre value (lgTCID50/cm2) | 4.07 × 105 | 9.35 × 104 | 8.33 × 103 | 93.50 |
| Antiviral activity value (R-value) | - | - | 1.05 | 3.00 |
| Antiviral activity rate (%) | - | - | 91.1 | 99.9 |
| Animal Number | Sodium Chloride Solution Extract | Scoring Interval (Erythema Site/Edema Site) | |||
|---|---|---|---|---|---|
| Immediately after Injection | 24 h | 48 h | 72 h | ||
| Rabbit A | From ERF-A with 3% PHMB | 0/0 | 0/0 | 0/0 | 0/0 |
| From control | 0/0 | 0/0 | 0/0 | 0/0 | |
| Rabbit B | From ERF-A with 3% PHMB | 0/0 | 0/0 | 0/0 | 0/0 |
| From control | 0/0 | 0/0 | 0/0 | 0/0 | |
| Facility | Control | 3D-Printed Cover | Inhibitory |
|---|---|---|---|
| (CFU/mL) | (CFU/mL) | (%) | |
| Door’s pulling handle of exhibition hall on the 1/F | 45 | 2 | 95.6 |
| Push button of faucet at the park entrance | 16,000 | 14 | 99.9 |
| Surface of stainless-steel tray at ticket counter | 520 | 78 | 85.0 |
| Door lock of toilet cubicle in males’ toilet on the G/F | 183.5 | <1 | ≥99.5 |
| Ventilation window in toilet cubicle in males’ toilet on the G/F | 130 | 7 | 94.6 |
| Contact Hour of Bacteria | ||||
|---|---|---|---|---|
| Sample | S. aureus (CFU/mL) | E. coli (CFU/mL) | ||
| 0 h | 24 h | 0 h | 24 h | |
| Covers for ticket counter (Normal) | 0 | 0 | 0 | 0 |
| Covers for ticket counter (Abraded) | 0 | 0 | 4.10 × 107 | 0 |
| Door lock of toilet cubicle (Normal) | 0 | 0 | 0 | 0 |
| Door lock of toilet cubicle (Abraded) | 0 | 0 | 0 | 0 |
| Bar on ventilation window (Normal) | 1.31 × 106 | 0 | 3.10 × 109 | 0 |
| Bar on ventilation window (Abraded) | 1.21 × 106 | 0 | 4.50 × 104 | 0 |
Disclaimer/Publisher’s Note: The statements, opinions and data contained in all publications are solely those of the individual author(s) and contributor(s) and not of MDPI and/or the editor(s). MDPI and/or the editor(s) disclaim responsibility for any injury to people or property resulting from any ideas, methods, instructions or products referred to in the content. |
© 2024 by the authors. Licensee MDPI, Basel, Switzerland. This article is an open access article distributed under the terms and conditions of the Creative Commons Attribution (CC BY) license (https://creativecommons.org/licenses/by/4.0/).
Share and Cite
Luk, A.M.Y.; Lo, C.K.Y.; Chiou, J.A.; Ngai, C.-H.; Law, K.; Lau, T.-L.; Chen, W.-X.; Hui, M.; Kan, C.-W. Antiviral and Antibacterial 3D-Printed Products Functionalised with Poly(hexamethylene biguanide). Polymers 2024, 16, 312. https://doi.org/10.3390/polym16030312
Luk AMY, Lo CKY, Chiou JA, Ngai C-H, Law K, Lau T-L, Chen W-X, Hui M, Kan C-W. Antiviral and Antibacterial 3D-Printed Products Functionalised with Poly(hexamethylene biguanide). Polymers. 2024; 16(3):312. https://doi.org/10.3390/polym16030312
Chicago/Turabian StyleLuk, Anson M. Y., Chris K. Y. Lo, Jiachi Amber Chiou, Chi-Hang Ngai, Ki Law, Tsz-Long Lau, Wan-Xue Chen, Matthew Hui, and Chi-Wai Kan. 2024. "Antiviral and Antibacterial 3D-Printed Products Functionalised with Poly(hexamethylene biguanide)" Polymers 16, no. 3: 312. https://doi.org/10.3390/polym16030312
APA StyleLuk, A. M. Y., Lo, C. K. Y., Chiou, J. A., Ngai, C.-H., Law, K., Lau, T.-L., Chen, W.-X., Hui, M., & Kan, C.-W. (2024). Antiviral and Antibacterial 3D-Printed Products Functionalised with Poly(hexamethylene biguanide). Polymers, 16(3), 312. https://doi.org/10.3390/polym16030312

